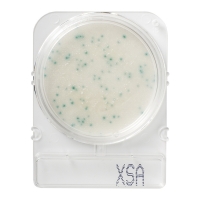
Подложки Compact Dry XSA (золотистый стафилококк), 40 шт.

Главная Каталог товаров Микробиология Подсчет колоний Счетчик колоний G-330 с ПО на USB-накопителе
Описание
Счетчик колоний с лупой на штативе и настраиваемым держателем для чашек Петри. Оснащен кольцевой светодиодной подсветкой с возможностью регулировки. На дисплее одновременно отображается текущее значение и результаты трех предыдущих подсчетов. Особая конструкция датчика давления позволяет использовать для маркировки любую ручку без риска загрязнить материал. Имеется функция усреднения подсчетов и кнопка, отменяющая ввод неверного значения. Прилагается USB-накопитель с лицензионным программным обеспечением, предоставляющим возможность поиска, добавления и удаления данных, а также составления и печати отчетов. Соединительный кабель для ПК в комплекте. Прибор соответствует требованиям стандартов CE.